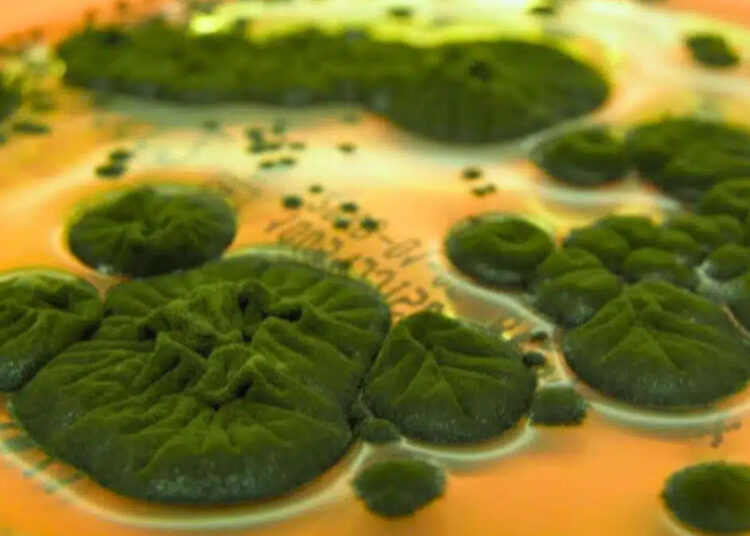
Researchers confirm that a fungus in Chernobyl could use radiation as an energy source, changing everything we knew 1 Researchers confirm that a fungus in Chernobyl could use radiation as an energy source, changing everything we knew

Researchers confirm that a fungus in Chernobyl could use radiation as an energy source, changing everything we knew
The Chernobyl Nuclear Power Plant explosion happened nearly 40 years ago, but the exclusion zone is still dangerous for people. ...
Read more